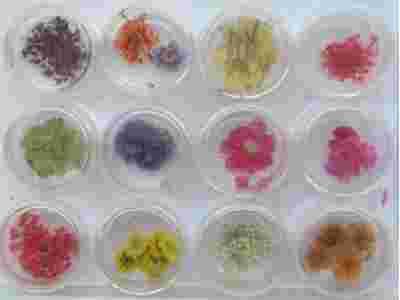

O mnie
MojeAukcje
MojeKomentarze
Dodaj doUlubionych
|
|
E-mail: [zasłonięte]@epoczta.pl
Nr tel.: (0) 504 [zasłonięte] 704
Gadu-Gadu: 15[zasłonięte]593
|
POCZTA POLSKA
6,00 PLN - list polecony priorytetowy
FIRMA KURIERSKA SIÓDEMKA
13,00 PLN - Paczka
15,00 PLN - Paczka za pobraniem
NA ŻYCZENIE KLIENTA
KURIER DPD
20,00 PLN - wysyłka kurierska DPD
25,00 PLN - wysyłka kurierska pobraniowa DPD
POCZTA POLSKA
15,00 PLN - paczka priorytetowa
20,00 PLN - paczka priorytetowa za pobraniem
|
|
Kupując na kilku naszych aukcjach, za przesyłkę zapłacisztylko raz!
Na życzenie klienta wystawiamy fakturę VAT!
|
|
1. Wtytule przelewu podaj swój nick (nazwę użytkownika) z Allegro - inaczejzamówienie może zostać znacznie opóźnione lub wogóle nie zostaniezrealizowane.
2. Na wpłatę czekam do 14 dni. Po upływie tego terminuwystawiam negatywny komentarz.
3. Po zakupie na mojej aukcjikoniecznie wyślij do mnie e-mail z wybranymi przez siebie kolorami (wzależności od rodzaju aukcji).
4. Proszę również Kupujących oinformowaniu mnie o sposobie wysyłki (wpłata na konto, czy płatność przyodbiorze).
5. Towar wysyłam w ciągu 24h od złożenia zamówienia (przyopcji za pobraniem), lub otrzymaniu wpłaty na konto:
71 1050 [zasłonięte] 146100 [zasłonięte]30[zasłonięte]39
49 1140 [zasłonięte] 201700 [zasłonięte]20[zasłonięte]09
|
Na niniejszej aukcji masz okazję kupić:
MEGA DUŻY ZESTAW
12 słoiczków
RÓZNYCH KWIATKÓW SUSZONYCH
W POJEMNICZKACH
W 12 RÓŻNYCH KOLORACH
DOKŁADNIE TAKIE JAK NA FOTOGRAFII
TYLKO U MNIE
SERDECZNIE ZAPRASZAM DO ZAKUPU
Po zakupie proszę o e-mail z wybraną formą wysyłki (wpłata/pobranie).
| GALERIA |
magdaszewczyk - W Y B R A N E O F E R T Y |
© 2[zasłonięte]005-20
Net_Studio |
? |
|
|
|